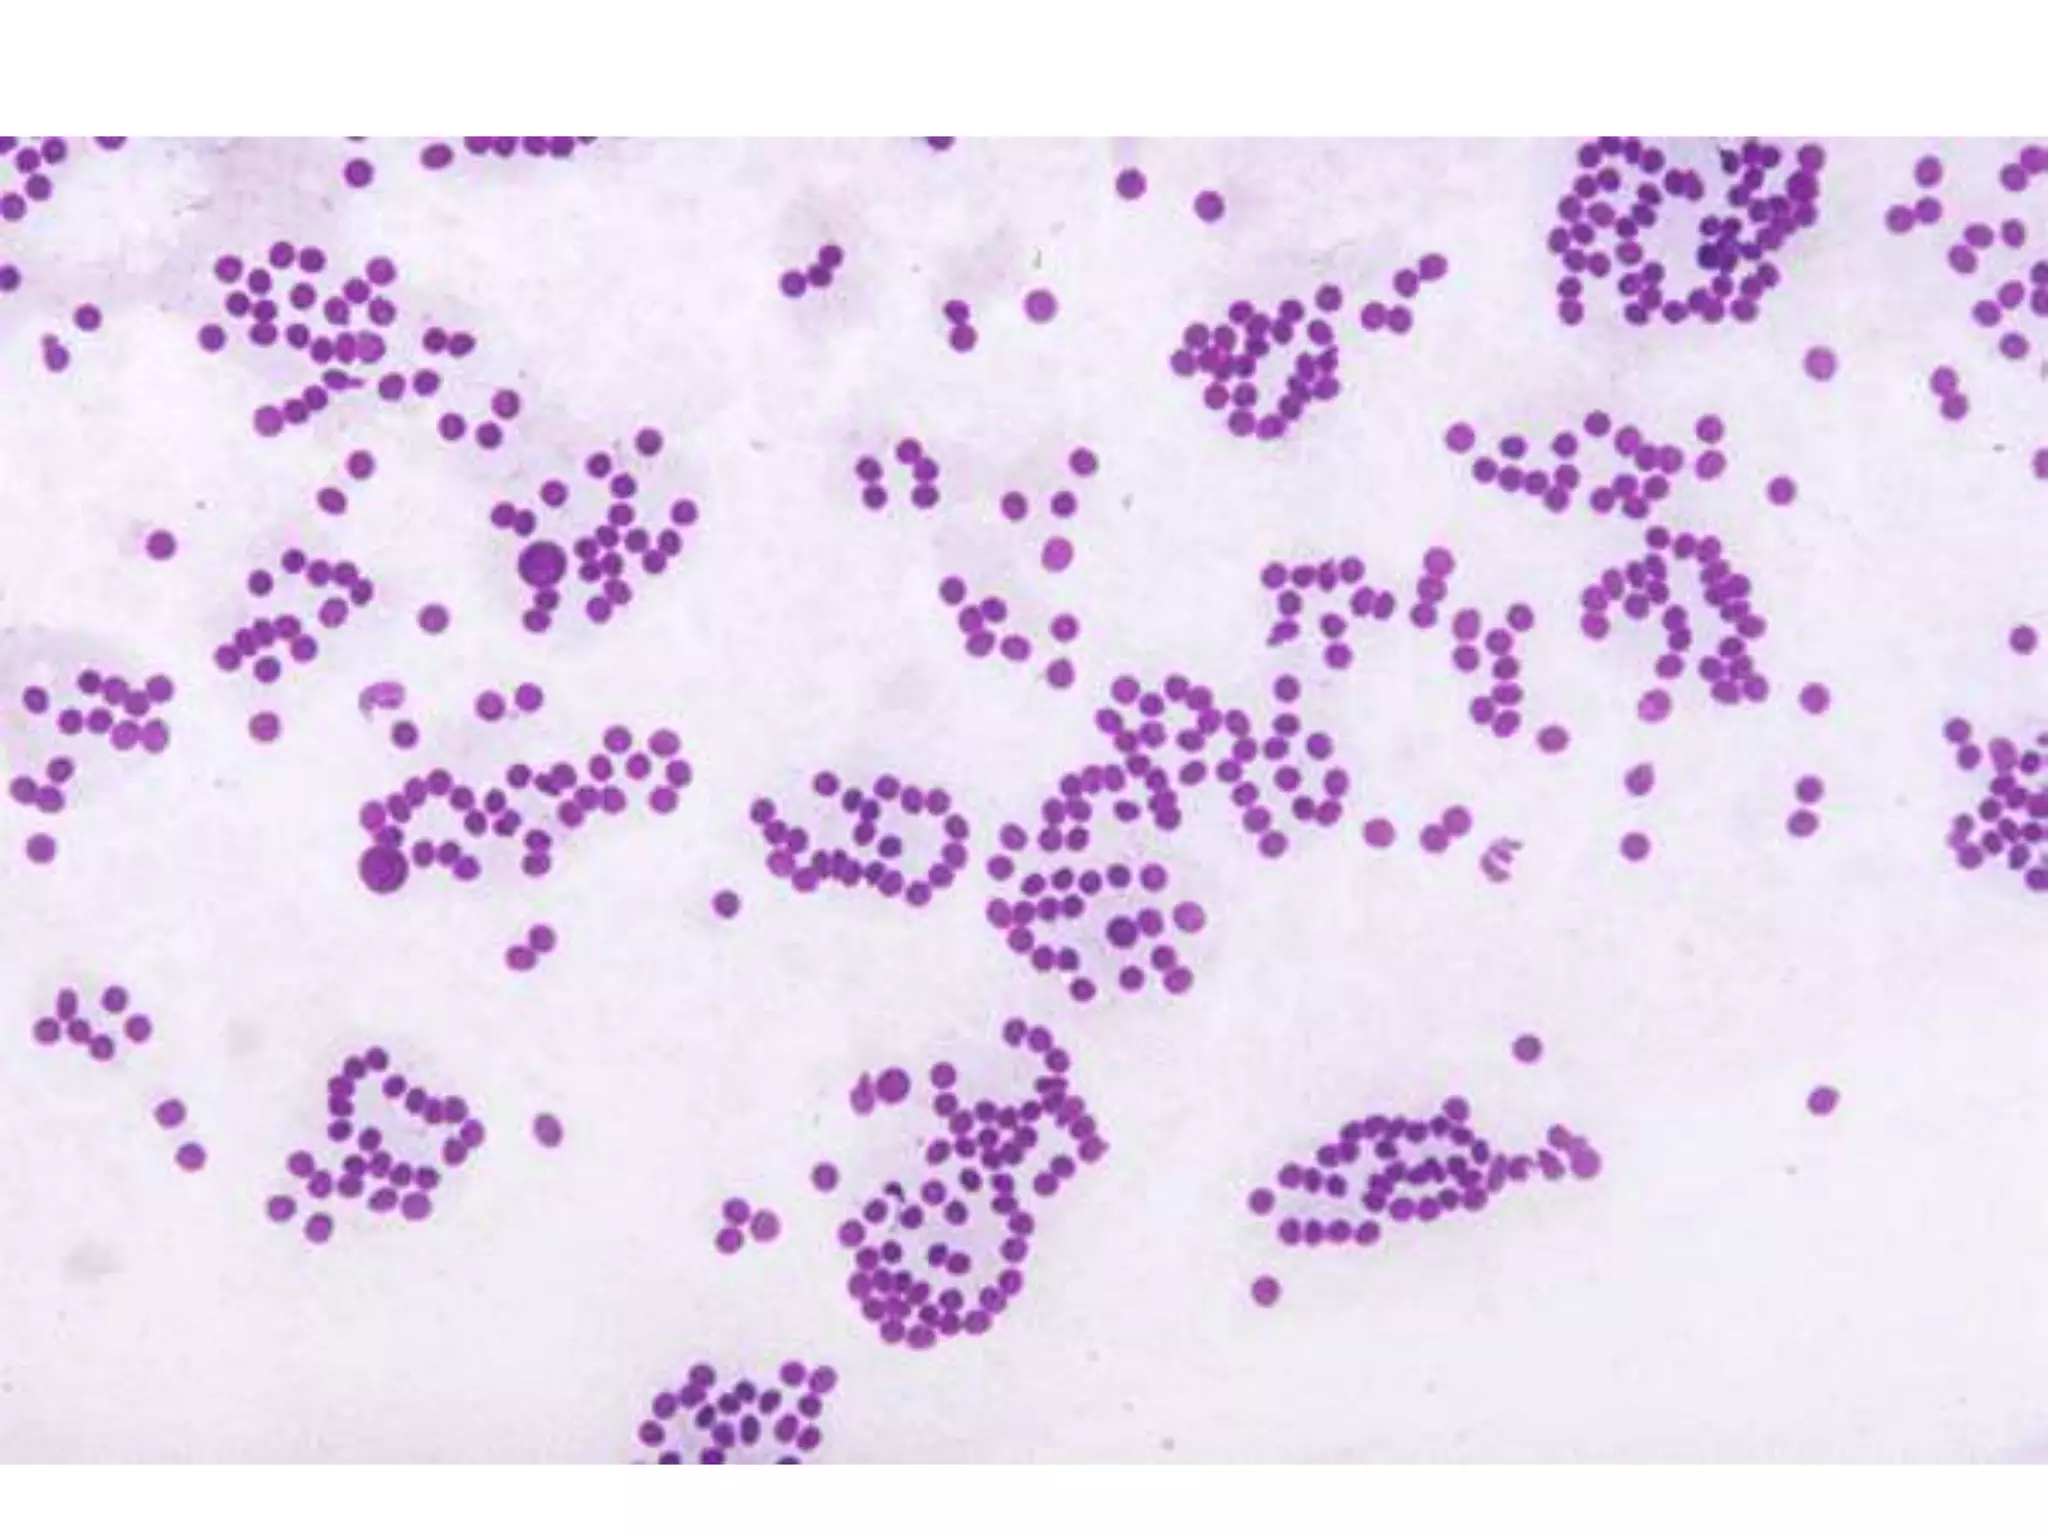

This document discusses cytopreparatory techniques for cytology samples. It describes the different types of cytology samples like exfoliative cytology, aspiration cytology, and body fluids. The key steps in cytopreparatory techniques are outlined as evaluation of specimens, preparation of smears, fixation, and staining. Factors that can affect optimal cytological preparation like quality of specimen, fixative used, and stains are also summarized. Different fixation techniques including dry, wet, liquid-based, and lysing fixation for bloody samples are explained.